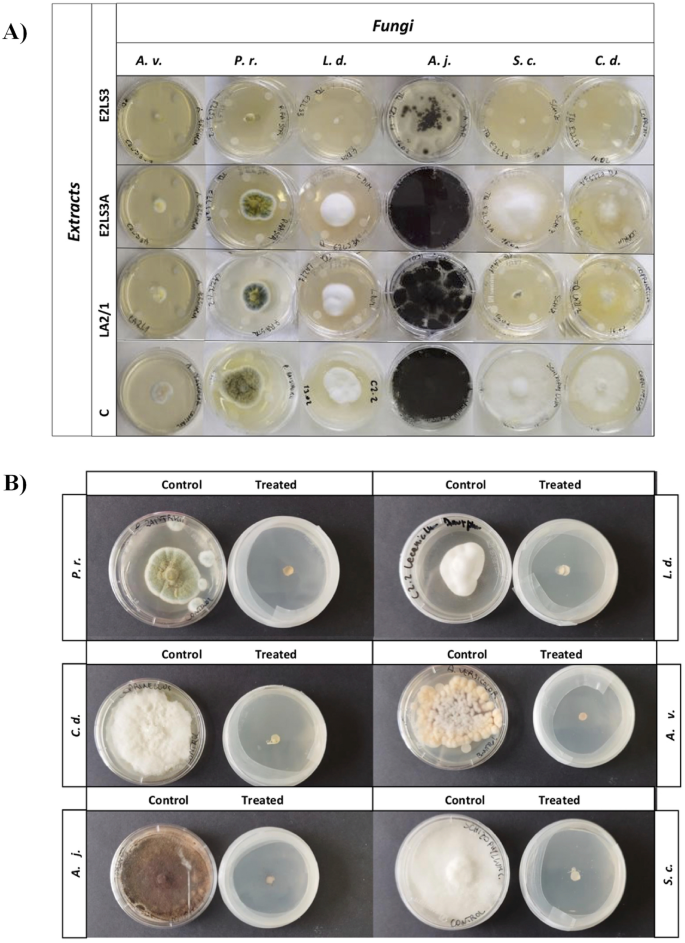
Fig. 5

Abstract
In the context of bio-deterioration of cultural heritage, the Lavandula angustifolia Mill. plant proves to be of interest for a green approach to the preservation of art manufacts on organic media. Supercritical CO2 fluid extraction (SFE) was utilized to obtain both lavender essential oil (E2LS3) and hydrolate (E2LS3A), while ultrasound assisted maceration in n-hexane:ethanol (99:1, v:v) provided LA2/1 extract. The extracts, all chemically characterized by UHPLC-HRMS and GC–MS analyses, were screened for their antifungal capability towards six fungi isolated from the plywood support of Haim Steinbach's contemporary artwork "Un-color becomes alter ego #2" (1984). To this purpose, disk diffusion method was applied on both mycelium and conidial suspensions to unravel whether the inhibitory activity affects the growth of fungi at different life cycle stages. The micro-atmosphere method was also explored to assess the response of fungal growth in a saturated atmosphere. Data acquired highlighted that SFE-obtained lavender essential oil, whose oxygenated monoterpene part mostly accounting for terpinene-4-ol, borneol, linalool, camphor, and 1,8-cineole, proves to be a dose- and time-dependent inhibitor of fungal growth. It has also been shown that exposure to the oil vapor phase is more effective at very low dose levels. The promising results allow us to hypothesize the use of the essential oil for treating fungal colonization by exposure to its volatile components in a modified atmosphere environment, with no direct contact with the artwork.
Graphical abstract

Similar content being viewed by others
Introduction
Biodegradation of art manufacts is one of the most common causes of aesthetic damage in cultural heritage conservation. In particular, fungi, due to their adaptability and resistance to extreme thermo-hygrometric parameters, turn out to be present in different types of public, private and museum exhibition environments. Fungal colonization can be the cause of direct and indirect damages: the former consists of structural impoverishment and morphological alteration of the materials constituting the artworks, as a consequence of the enzymatic action against classes of molecules of which they feed on, such as cellulose, lignin, starches, proteins [1]. In addition, the development of mycelium on surfaces can cause physical–mechanical damage with associated problems of adhesion, micro-cracking, and de-cohesion [2]. Fungal colonization also acts indirectly, by causing biochemical changes as a result of the interaction of metabolites secreted by microorganisms (e.g. organic acids and pigmented compounds), which can modify pH values and catalyze oxidation processes of the original materials [3].
The degradation of biological origin impacts a diverse range of materials, encompassing not just those derived from nature used in traditional methods but also synthetic products present in modern poly-material artifacts and products utilized in restoration procedures. An example of bio-receptive synthetic compounds are petro-plastics (PVC, PP, PS, PET, PU) [3, 4], and acrylic paints and resins used in restoration [5]. Biocide treatments involving such types of poly-material works are complex due to the heterogeneity of their components, since each of them must be chemically and physically compatible with the applied product. The importance to find new alternatives to existing commercial products based on quaternary amonium salts stems not only from the desire for a greener solution but also from the risk of developing resistance by microorganisms [6].
Recently scientific research has focused on the use of alternative and eco-friendly products to conduct biocidal treatments on artistic manufacts, and the extensive literature demonstrates that plant-derived essential oils have achieved excellent results in ensuring inhibition against biological colonization, despite demonstrating an inconsistent trend [7,8,9,10,11,12,13]. Variabilities in antifungal efficacy are related to multiple factors. In fact, plant matrices vary widely in their composition in terms of secondary metabolites depending on the time and place of harvest [14,15,16], extraction method [17] and, within the same genus, on the species and cultivar [18]. Along with the intrinsic mutability of plant extracts, the anti-fungal properties have variable trends according to the concentration and time, as well as the specific sensitivity of the micro-organisms. Among plant extracts tested in the literature, antifungal properties of essential oils from plants belonging to the Lamiaceae family stand out. Within these aromatic and medicinal plants, extracts obtained from different lavender species (L. dentate, L. angustifolia, L. stoechas, L. latifolia, L. officinalis and their hybrids) were found to be effective in growth inhibition in in vitro experiments [8, 18,19,20,21,22,23]. In particular, literature data show that the effectiveness of lavender essential oil can reach a total fungal growth inhibition on fungal plant pathogens by direct contact starting from 0.032% [24,25,26,27] and by vapour phase at 0.018% [28, 29] of concentration on the total volume to treat (v/v). However, although the antifungal efficacy of lavender extracts is extensively documented, data on its application in the context of cultural heritage, and specifically on organic media, is very limited [13, 21]. These studies focus primarily on in vitro activity without considering the applicative aspects and implications on art objects and, furthermore, no contemporary polymaterial artwork has been considered as an experimental target so far. Other studies mention the use of essential oils such as clove, thyme, rosmary, basil, mint ect. [28, 30,31,32,33,34,35,36,37,38] used on wooden materials, archival documents and canvas paintings with few or no references to the extraction processes and selection of bioactive compounds from plant matrices, and how these influence the antifungal effectiveness of the treatment.
The present research arises from multiple needs: not only to assess the feasibility of utilizing lavender extract as an alternative biocidal treatment for artistic artifacts, but also to contemplate the use of a sustainable extraction technique to obtain it. Secondly, in order to minimize the quantity of substance used, different application methodologies have been evaluated to identify the most effective and suitable for the restoration sector.
In the specific context of the case study involving a contemporary art object, proposing an alternative and non-contact application protocol proves to be essential in minimizing the direct application of substances onto the artwork's surface, which presents compositional heterogeneity.
Research aim
The present research aims to: (1) investigate whether and to what extent the extraction processes influence the yield of the plant matrix of Lavandula angustifolia in terms of chemical composition and antifungal properties; (2) identify the most effective application method for the antifungal treatment of complex multi-material works through contact and non-contact protocols.
Materials and methods
The artwork
"Un-color becomes alter ego #2" is the name of the artwork used as case study. It was realized in 1984 by the artist Haim Steinbach; it is part of the permanent collection of the Plart Foundation and it is exhibited in the homonymous Museum of Design and Plastic Art in Naples, Italy. It is a poly-material object of contemporary art: it consists of a shelf made of plywood covered in laminate and includes two latex masks of Yoda and a music stereo (Fig. 1A). The support affected by bio-colonization is the wooden substrate, which has shown signs of degradation manifesting as a powdery white appearance (Fig. 1B).
A The artwork "Un-color becomes alter ego #2"; B Verso of the artwork: on the wooden surface of the shelf the fungal degradation is identified in the white powdery substance; C Collection of biological materials
Fungi isolation: morphological characterization and molecular identification
The fungi isolation has been carried out in situ at the Plart Museum in Naples, from the surface of the artwork plywood support using a sterile scalpel (Fig. 1C). The biological material was placed in Petri dishes (60 mm diameter) on sterilized Potato Dextrose Agar (PDA; Conlab®) culture medium. The plates were incubated in the dark for 7 days at 22 ± 2 °C. Thus, 14 fungi were isolated.
Morphological characterization was performed by observing macroscopic characteristics such as colony color and growth rate of fungal colonies isolated on PDA. Furthermore, under the optical microscope (Olympus BH-2), the fruiting bodies and conidia produced by 10–14 day old mushroom cultures grown on PDA plates were observed, using water as a mounting medium.
To proceed with the identification of the isolated fungal species, DNA was extracted using Cetyltrimethylammonium bromide (CTAB) method [39], and then amplified through Polymerase Chain Reaction (PCR) technique in a thermal cycler. ITS1 and ITS4 primers were selected to replicate the gene sequences of all the isolates. Furthermore, the Translation Elongation Factor was used when the similarity percentage of gene sequences was lower than 99%. The procedure consisted in the following steps: heat activation at 94 °C for 2’ (Initialization), then 35 cycles at 94 °C and 55 °C for 30’’ for DNA melting (Denaturation), in order to bind the primers to the strands, the T is brought to 72 °C for 1’ (Annealing) and kept at this condition for 5 more minutes to allow the amplification (Extension). The samples are kept in the thermal chamber for cooling at 12 °C.
DNA was quantified by using UV–Vis Thermo Scientific™ NanoDrop™ One and visualized on an agarose gel to assess the concentration. In total, 12 DNA samples were diluted in distilled water to obtain a concentration of 10 ng/μL in a total of 25 μL of solution. Sequencing has been performed by BMR Genomics in Padua. The identified sequences have been uploaded on Chromas Lite software in order to clean the data, and in conclusion they were compared with the dataset from BLAST Nucleotide platform to identify fungal species based on % of similarity.
Plant material and extraction
Aerial parts of Lavandula angustifolia Mill. were collected manually in July 2022, at the “Delle Cave” farm, located in the municipality of Vitulazio (Caserta, Southern Italy—41°8′52" N 14° 12′37" E). The collected plant materials were dried in a ventilated oven at 45 °C for 5 days, and then pulverized (Knife Mill PULVERISETTE 11, Buch & Holm, Herlev, Denmark). Samples of dried lavender powder underwent extraction by means of supercritical fluids, or alternatively extracted by ultrasound-assisted maceration.
Supercritical CO2 extraction
Supercritical CO2 extraction was carried out at Mater s.r.l. (Naples) by a custom-built pilot plant, which is depicted in Additional file 1: Fig. S1, consisting in a 7 L extractor E1 (with 5 L internal basket) and three separation stages—a gravimetric 1 L separator S1, and two cyclonic separators S2 and S3 (0.5 L volume each). Two automatic back pressure regulators located downstream from E1 and S1 respectively allow for independent pressure settings in these two vessels. A water jacket heating system connected to a heater (Handy 4 K, Sella, Settimo Torinese, Italy) is used to maintain set temperatures at E1, S1, and S2, which can be varied from room temperature to 80 °C. The last separator S3, which is used to trap volatile compounds, and a CO2 reservoir B1 are cooled by a cold-water jacket connected to a chiller (RAK.E 2802 VH, Euroklimat, Siziano, Italy). Heating and cooling circuits are also used for various heat exchangers (H1-3, C1). The reservoir B1 allows to recycle CO2 thus drastically reducing its consumption. The plant uses a diaphragm metering pump by LEWA GmbH, Leonberg, Germany, model LDD1. Both the pump PCO2 and the extractor are rated for the maximum operating pressure of 300 bar, while the maximum CO2 flow rate is 33 kg/h. The pilot plant is controlled by a PLC and SCADA that allow to automatically execute an extraction cycle with preset parameters. The CO2 cylinder pack (FOODSENSE 2 grade, > 99%) was supplied by Nippon Gases Italia. A total of 1315 g of dry powdered lavender matrix was extracted employing the following parameters: in the extractor T = 50 °C, P = 100 bar, and in the S3 separator T = 15 °C. The CO2 flow was set for 30 kg/h for three hours for a total CO2 = 90 kg. Under these conditions the pure lavender essential oil extract (E2LS3) and the flavored water, the hydrolate (E2LS3A), were both collected in the S3 separator. Then the two phases, lipophilic and aqueous, were separated by decanting.
Ultrasound assisted extraction
Lavender chalices (20 g) underwent ultrasound-assisted maceration (UAM; Branson UltrasonicsTM BransonicTM M3800-E, Danbury, CT, USA) using n-hexane:ethanol (99:1, v:v) as extractive solution. The plant material:extractant ratio was of 1:10 (g:mL). Three UAM cycles were carried out (30 min for each) away from light. At the end of each cycle, the sample was filtrated, and dried by using a rotary evaporator (Heidolph Hei-VAP Advanyage, Schwabach, Germany). Thus, the extract LA2/1 was obtained.
Chemical characterization of lavender extracts
UHPLC ESI QqTOF HRMS/MS analyses
The three lavender extracts E2LS3, E2LS3A and LA2/1 were injected at a concentration level of 10 mg/mL. The separation was carried out by a NEXERA UHPLC system (Shimadzu; Tokyo, Japan) using a Luna® Omega C-18 column (1.6-μm particle size, 50 × 2.1 mm i.d.). A binary solution was utilized: (A) H2O and (B) CH3CN, both acidified with 0.1% of formic acid. A linear gradient was employed and solvent B percentage increased as follows: 0–1.0 min, 50% B; 1.0–10.0 min, 50 → 95% B; 10.0–13.0 min, held at 95%. Then, the mobile phase composition was allowed to re-equilibrate for 2 min. The flow rate and the injection volume were 0.5 mL/min and 2.0 µL, respectively. High-Resolution Mass Spectrometry (HR-MS) analyses were performed using the AB SCIEX Triple TOF® 4600 (AB Sciex, Concord,ON, Canada) system. This latter was equipped with a DuoSpray™ ion source, using ESI probe for MS investigations in negative ionization mode, and the APCI probe for fully automatic mass calibration (through Calibrant Delivery System). A full-scan time-of-flight (TOF) survey (accumulation time 100 ms, 100–1500 Da) and IDA MS/MS scans (dwell time 100 ms, 80–1300 Da) were acquired with the following parameters: curtain gas (CUR) 35 psi, nebulizer (GS1) and heated (GS2) gases 60 psi, ion spray voltage (ISVF) 4500 V, ion source temperature (TEM) 600 °C, and declustering potential (DP) − 80 V. The collision energy (CE) applied was − 40 V, with a collision energy spread (CES) of 20 V. The instrument was controlled by Analyst® TF 1.7 software (AB Sciex, Concord, ON, Canada,2016), while data processing was carried out using PeakView® software version 2.2 (ABSciex, Concord, ON, Canada, 2016).
GC–MS analysis
E2LS3 and LA2/1 extracts were diluted in n-hexane (1:30), while the aqueous extract E2LS3A was centrifugated with a solution of acetone and n-hexane (1:1) and the resulting supernatant was used for the analysis. For each sample 1 μL was injected in a GC–MS-QP2010 instrument (Shimadzu Corp., Kyoto, Japan) composed by GC-2010 Plus gas-chromatograph joint to a 2010 Plus single quadrupole mass spectrometer. A 30 m column (JB DB-WAX, 0.25 mm id, 0.25 μm film thickness, Agilent Technologies, Santa Clara, CA, USA) was used for compounds separation. Helium was the gas-carrier. The initial temperature of 38 °C was held for 1 min and then raised to 120 °C at a rate of 2 °C/min. The gas flow was set with a constant linear velocity at 45 cm/s, and the split ratio was set to 12:1. The mass spectrometer was set with a solvent cut time of 2.5 min. Before conducting the analysis a solvent blank was analyzed and for each sample five runs were carried out (duration of 99 min each). Peak areas were normalized on the detected signal strength, and the identification of metabolites was performed by comparing mass spectrum of each peak with the NIST library collection (NIST, Gaithersburg, MD, USA), considering the components matching for at least the 85%. This untargeted analysis was conducted without standard reference and allowed to obtain a relative and semi-quantitative composition of the extracts.
Antifungal activity tests
The antifungal properties of the above-mentioned extracts were evaluated by contact and by micro-atmosphere procedures. In the first case, the tests were carried out in Petri dishes (60 mm) in PDA-based culture medium using Disk Diffusion Method (Fig. 2A) [40]. To this purpose, 5 mL of Potato Dextrose Agar (PDA) were placed in each plate, while extracts were infused onto 4 mm diameter sterilized filter paper discs. These latter were placed equidistant from each other and imbibed with 10 μL of the mixture. In the middle of the plate, a mycelial plug was inserted with a 4 mm diameter hole-puncher. For the lavender essential oil (E2LS3) and hydrolate (E2LS3A) samples, pure extract and its dilutions, made using ethanol 96% (v/v) to achieve extract:solvent ratios equal to 3:1, 1:2, 1:3, and 1:4, were tested. The UAM-obtained dry lavender extract LA2/1 was dissolved in pure ethanol to reach a stock solution equal to 25 mg/mL, which was further diluted using extract:solvent ratios as above described.
Illustration of micro-biological essay protocols for A Disk Diffusion Method with mycelial plug, B Disk Diffusion Method using conidial suspension and C Micro-atmosphere with mycelial plug
For ascomycetous fungi, conidial suspensions were also prepared at a concentration of 1 × 105 CFU (colony-forming unit) to assess the susceptibility of the fungi at the pre-germination life-cycle stage (Fig. 2B).
For the second procedure in Micro-atmosphere (Fig. 2C) [13] the plugs of mycelium were inoculated on the medium, 40 μL of lavender essential oil (E2LS3), as such and following dilution ratios equal to 3:1, 1:2, 1:3, 1:4, 1:10, and 1:20, was applied on the lid of the reversed Petri plate. Thus, the evaporation of the volatile components without direct contact with the biological material was obtained. The plates were sealed with Parafilm® M to create a modified micro-atmosphere. Since both the apolar extracts and the hydrolate have high solubility in ethanol, this solvent has been preferred to surfactants to diluite the mixture. A control plate with untreated mycelium was made for each fungus in order to compare its growth; moreover another control plate for each fungus has been treated with ethanol in the same amount present in the corresponding tested diluition to ensure that the diluent did not interfere with the results of the extracts’ activity. For each sample three technical replicas have been carried out and and the experiment has been reapeted twice. Samples were stored in a thermostatic chamber at 24 °C for the period of the experiment. The results were monitored up to 2 months.
Statistical analysis
Data acquired were expressed as mean ± standard deviation (SD). ANOVA repeated measures followed by Tukey’s post hoc test was applied, using statistical SPSS software (version 20.0; SPSS Inc., Chicago, IL, USA).
Results and discussion
Fungi identification: molecular and morphological analysis
Six fungi were identified based on morphological observation and percentage of similarity of nucleotides allignments. The sequences were deposited on GenBank and their accession number is also reported. The colony of Aspergillus versicolor OR797125 (99%) reached 18 mm in diameter after incubating for 7 days on PDA at 25 °C. The surface was a color between pale yellow and orange, while reverse was light brown to orange. Conidia were sub-globose with 2.0–3.0 µm of length [41]. As for the Aspergillus japonicus OR793057 (100%), colonies reached about 5.3 cm in diameter in 7 days on PDA at 25 °C. The colonies at first were uncolored but later turned to black. Mature conidial heads were variable. Conidia were nearly globose to globose with a length of 2.5–3.5 µm [41] Morphological features of Penicillium raistrikii cultures OR793104 (100%) were studied considering the colony diameter growth rate of 47 mm in 7 days, and the yellowish-green color of the surface colony. Microscopic features for the identification were ellipsoid conidia, with a length of 3,5 µm [42]. Lecanicillium dimorphum OR789619 (100%), showed colonies reaching 2.2 cm in diameter in 7 days on PDA and were high, white and fluffy. Conidia length was in a range of 1.5–2.3 µm [43]. Schizophyllum commune mycelia OR789623 (100%) revealed both narrow and wide hyphal filaments, which were hyaline and septate. It turned to brown colour, the outline of colony was white, and the reverse of plate was darkened. Coprinellus domesticus OR789618 (100%) produced no characteristic mycelium on PDA, and its colony was white as for several other basidiomycetes. For both basidiomycetous fungi, identification was necessary to perform translation elongation factor as the ITS analysis only achieved 98% similarity to the dataset (Additional file 1: Fig. S2; Genetic Sequences). Since the isolates of S. commune and C. domesticus are difficult to identify and the production of basidiocarp is not easy, cumbersome and very high time-consuming, techniques such gene sequencing are required to identify these basidiomycetes [44, 45].
The six fungi mentioned were used for testing anti-fungal efficacy of the extracts. The presence of Aspergillus and Penicillium spp. as first settlers generates a more bio-receptive substrate and also predisposes it to a second colonisation. A. versicolor, a slow-growing filamentous fungus was recently found to infect organic-media artworks [46], there was no evidence for the other identified fungi. Isolated species of basidiomycetes such as Coprinellus domesticus and Schizophyllum commune are recognised as being responsible for white rot disease on wood due to their enzymatic activity against lignin and cellulose [47, 48]. The presence of Lecanicillium dimorphum, an entomopathogenic fungus found on plant leaves and stems, can also interfere with the colonisation process due to its enzymatic activity towards the starch naturally present on these substrates, thus representing a species relevant to the bio-degradation process [49].
Extracts yields
Based on applied supercritical CO2 extraction conditions, E2LS3 extract yield was 1.36% on a dry mass basis (%g oil/100 g dry lavender), while the recovery of the aqueous part (E2LS3A) corresponded to 1.44%. UAM-based extract LA2/1 scored higher extraction yield (5.28%).
Although the percentage yield of lavender essential oil by supercritical fluid extraction appears lower than that obtained by UAM, SFE is known to be a sustainable alternative that provides extracts with high purity. When compared to data in the literature, it becomes apparent that the extraction yield obtained is consistent with findings from some previous studies, which indicate a recovery rate even below 1% [50]; nevertheless, it is lower than the extraction yields reported in other research [51]. However, it should be emphasized that the applied parameters of temperature, pressure, etc. extensively affect the yield and purity of the final product [52]. In fact, studies have shown that extending the exposure time, along with adjusting pressure and temperature parameters, promotes the production of essential oils containing a higher quantity of impurities, mainly due to waxes and pigments, such as chlorophylls and flavonoids [50, 53]. Similar components, as revealed by analyses in liquid chromatography and/or gas chromatography coupled with mass spectrometry, are absent in the extracts herein discussed.
Chemical characterization: UHPLC-HRMS and GC–MS data
In order to determine the chemical composition of the extracts under investigation, both UHPLC-HRMS and GC–MS tools were applied, and compounds belonging to different chemical classes, mainly terpenes and fatty acids, were identified.
In particular, UHPLC-HRMS highlighted that LA2/1 extract mainly consisted of fatty acids and triterpene compounds (Table 1).
Ursane-type triterpenes, such as ursolic acid, and its dehydroderivative, previously isolated from L. spica and L. austrappenina, were detected, together with 3-oxo-hydroxyurs-12-en-28-oic acid and its dehydroderivative. This latter showed the deprotonated molecular ion at m/z 467.3171. Coumarate esters were also tentatively identified, while the polyunsaturated fatty acid linoleic acid appeared to be the most abundant fatty acid of the extract. Palmitic acid, oleic acid and linolenic acid were largely in E2LS3 extract, while the aromatic water accounted for linalool hexoside and monosaccharides.
The relative quantitation of the compounds tentatively identified allowed a heatmap construction. In fact, a multivariate analysis approach by ClustVis (https://biit.cs.ut.ee/clustvis/) was applied to investigate and clarify quali-quantitative compositive data of compounds in each extract. The graphical representation clearly highlighted that the three extracts broadly differed in the relative content of their constituents (Fig. 3).
Heatmap of the compounds tentatively identified in the lavender extracts (https://biit.cs.ut.ee/clustvis/). In the ClustVis hierarchical clustering tool, both rows and columns are clustered using correlation distance and average linkage
To fully deepen the chemical composition of the three extracts, volatile compounds were analyzed by means of GC–MS techniques. In particular, when GC–MS analysis were carried out, more than three hundred compounds for each extract were tentatively identified; the main ones present at a concentration ≥ 1% are shown in Table 2. Although the relative intensities of LC–MS and GC–MS peaks do not directly correlate to absolute concentrations, due to the differential ionization efficiencies of the different metabolites within a complex mixture [54], terpinen-4-ol appeared to be the most abundant compound in E2LS3 extract. This latter further accounted for borneol, linalool, camphor, and 1,8-cineole. Terpinen-4-ol content decreased in E2LS3A, where linalool and borneol constituted together the 56.3% of the constituents, and in LA2/1 extract. This latter, according to UHPLC-HR MS profile, contained an hydroxycinnamyl derivative, and fatty acids among its components. Furthermore, 1,8-cineole, which appeared to be lacked in E2LS3A extract, was poorly in LA2/1 extract, which in turn did not contain borneol at dose level ≥ 1%.
Considering the monoterpene component of the three investigated extracts, as sum of monoterpene hydrocarbons and oxygenated monoterpenes, E2LS3 and E2LS3A extracts appeared to be the richest, whereas E2LS3A also contained monosaccharides.
Terpinene-4-ol was previously detected in apolar lavender extracts obtained by using n-hexane in maceration processes, and by means of supercritical fluids, although found in considerably lower quantities than in the present study (0–6%) [9, 21, 25, 27,28,29]; while common main compounds such as linalool, lavandulol and linalyl acetate are present in lower quantities than in the range indicated for oils from samples of Lavandula angustifolia collected in Italy [30, 31].
Antifungal activity tests
Disk diffusion method with mycelial plug
E2LS3 extract inhibited the radial growth of all the isolated fungi in a dose- and time-dependent trend (Fig. 4), while E2LS3A, and LA2/1 extracts did not show any effect (Fig. 5A). The data was expressed as a percentage of fungal growth relative to the considered exposure time: the percentage was calculated by comparing the growth diameter (mm) of the treated samples with their respective control plates, with the control at that time being equal to 100%., In particular, the data recorded at 5, 7, and 10 days after treatment highlighted that the SFE-obtained oil was broadly effective at the highest dilutions tested. In fact, when it was inoculated in its pure form or diluted in 3:1 ratio, maximum growth inhibition (100%) was observed (data not shown). The 1:2 dilution also exhibited 100% inhibition towards all the fungi at 5 days exposure time, with the exception of Aspergillus japonicus, which appeared to be more resistant to the oil treatment. The effect was strongly time-related with an inhibition equal to 58.3% after 5 days exposure, and to 9.4% 10 days after the incubation. When dilution ratios 1:3 and 1:4 were tested, Schizophyllum commune, a mushroom able to grow on decaying wood, was massively inhibited after five treatment days, and preserved the inhibitory ability after 7 days of exposure. It was observed that the increase in dilution ratio accounted for a time-related decrease of the antifungal efficacy. Excellent inhibitory ability (> 90%) was also demonstrated at 1:3 dilution ratio towards Coprinellus domesticus, Aspergillus versicolor, and Lecanicillium dimorphum, while the same dose exterted an inhibition equal to 89.7% vs. Penicillium raistrikii. Generally, a minor but still important efficacy was recorded after 10 days of treatment after 10 days, whereas 50% inhibition was maintained for the 1:3 oil sample vs. Lecanicillium dimorphum, Penicillium raistrikii and Coprinellus domesticus. The inhibitory activity of E2LS3 extract could be due to its chemical composition, and in particular to its differentiable content in linolenic and oleic acids, and its diversity in oxygenated monoterpenes, especially 1,8-cineole. In fact, although terpinene-4-ol, which was shown to be active agains Aspergillus spp. and Penicillium spp. [56], appeared as the main constituent, 1,8-cineole, also known as eucalyptol, was previously reported as able to exert antifungal and anti-biofilm activity [31]. The different response of E2LS3 and E2LS3A suggests that the ratio among constituents play a fundamental role in the antifungal activity.
Percentage of Inhibition of Lavender essential oil (E2LS3) tested through Disk Diffusion Method at the three different considered dilutions towards Coprinellus domesticus, Schizophyllym commune, Aspergillus versicolor, Aspergillus japonicus, Penicillium raisttrikii and Lecanicillium dimorphum. Presented results express the values of inhibition after 5, 7 and 10 days of treatment. The results are shown as mean ± SD of two independent experiments, each of which was performed in three replicates
A Antifungal activity test through Disk Diffusion Method using mycelial plug. Results of fungi treated with LA2/1, E2LS3A and E2LS3 at maximum concentration. B Antifungal activity test through Micro-atmosphere (left plates = Control; right plates = treated mycelium plug): 40μL of E2LS3 extract placed on the lid of an overturned Petri plate. Aspergillus versicolor (A. v.), Aspergillus japonicus (A. j.), Coprinellus domesticus (C. d.), Lecanicillium dimorphum (L. d.), Penicillium raistrikii (P. r.), and Schizophyllum commune (S. c.)
Disk diffusion method with conidial suspension
With regard to the four ascomycetous fungi (Aspergillus versicolor, Aspergillus japonicus, Penicillium raistrikii, Lecanicillium dimorphum), the susceptibility tests using conidia confirmed the results obtained on mycelium, once again highlighting the effectiveness of the E2LS3 extract. Again, the minimum effective dose levels vary according to the fungal species, with Aspergillus japonicus being inhibited when dilution ratios 1:3 and 1:2 were considered (13.3 μL and 20 μL, respectively on 40 μL). The other three fungi were inhibited using dilution ratios 1:3 and 1:4 (13.3–10 μL). Based on SFE-obtained oil volume required to inhibit fungal growth in relation to the plate volume, the percentage of extract to be used (v/v) in relation to the total volume to be treated was estimated. Thus, it was calculated that essential oil should be between 0.71%- 1.08% for eradicating Aspergillus japonicus, while a percentage between 0.13%-0.18% could be required for counteracting the other three ascomycetous fungi.
Antifungal activity assessed by micro-atmosphere method
Susceptibility test by fumigation in microatmosphere showed that E2LS3 exerted an important antifungal efficacy also when 1:10 and 1:20 dilutions were considered. The growth inhibition up to 10 days was equal to 100% for all the mushrooms at 1:2 dilution (Fig. 5B). Analogously, the growth of Penicillium raistrikii, Aspergillus versicolor, Schizophyllum commune and Lecanicillium dimorphum was completely inhibited when the 1:3 dilution was tested, while Coprinellus domesticus was inhibited by 70%. The complete inhibition for three out of six fungi was also recorded when testing 1:4 dilution, while the radial growth of Schizophyllum commune and Coprinellus domesticus was reduced by 60% (Fig. 6). Although a time-dependent efficacy decrease was observed following the treatment with the 1:10 and 1:20 dilutions, Lecanicillium dimorphum and Penicillium raistrikii growth still appeared to be affected. Samples that achieved complete inhibition (100%) were monitored for up to 8 weeks and treatment efficacy did not change over time.
Inhibitory activity (%) of lavender essential oil (E2LS3) tested through Micro-Atmosphere at the considered dilutions (1:2; 1:3; 1:4; 1:10; 1:20) towards isolated fungi after 5, 7 and 10 days. The results are shown as mean ± SD of two independent experiments, each of which was performed in three replicates
To assess the IC50 value for each assayed fungus, graphs on the percentage of inhibition were linearized using a probit statistical model [57]. The linear model was used to graphically identify to which value of the logarithm of the essential oil concentration corresponds the probit coefficient associated with 50% inhibition (Y = 5). By graphically intercepting the trend curve of each fungus inhibition at the above probit value, it was possible to define the concentration required to inhibit the radial growth by 50% (IC50). The IC50 of lavender essential oil reached by Disk Diffusion Method (DDM) and by contactless application (M-A) were compared and the higher efficacy of Micro-Atmosphere in terms of minimal quantity (µL) emerges (Table 3).
The use of lavender essential oil in the micro-atmosphere has already shown good results in previous studies, although with a considerable variability depending on the tested fungal species [28, 58, 59]. This study highlights how the same extract can perform better depending on the application protocol, demonstrating inhibitory properties as low as 0.0008% concentration (the percentage refers to µL of essential oil on the volume of the air in the Petri dish, which is approximately 18 mL) but efficacy must be evaluated on a case-by-case basis depending on the sensitivity of the microbial consortium considered. Some previous case studies report the use of raw essential oils applied directly [13, 23, 32,33,34,35] and indirectly [13, 34,35,36,37,38] on artworks on organic support. It is interesting to highlight how, differently from the present case study, the microbiological tests present in the literature have shown less efficacy in micro-atmosphere than the contact treatment [13, 38] or have required a direct application to integrate the treatment inefficiency [35, 37]. This comparison once again highlights the intrinsic variability of the anti-fungal properties of plant extracts in relation to the species examined, for which it is difficult to identify a standard and unambiguous profile of efficacy and applicability. Concerning the feasibility of this protocol in the current case study, considering the size of the artwork’s total volume of 0.260 m3, it is estimated that 120 ml of lavender essential oil would be necessary (based on a 0.048% concentration on the total air volume to ensure complete growth inhibition of all isolated fungal species). This quantity should be introduced alongside the object within a confined environment for fumigation treatment. While the strength of this experimental approach lies in its straightforward execution and minimal direct impact on the work's surface, a significant challenge arises in the quantitative yield of the extraction process. The extraction yield of lavender essential oil using supercritical carbon dioxide is below 2%, necessitating a substantial amount of plant material.
Future research efforts should concentrate on refining large-scale environmentally friendly extraction processes to enhance the quantitative yield without compromising compositional purity.
Conclusions
The applicability of Lavandula angustifolia for preserving cultural heritage was investigated through the preparation of polar and apolar extracts. To this purpose, different extraction techniques were exploited, and protocols emulating contact and indirect exposure were investigated.
Data acquired highlighted that lavender essential oil obtained by supercritical CO2 extraction may be used as a potential biocide in the conservation of artistic objects on organic support. Specifically, the high efficacy achieved through exposure to the vapor phase of the oil allows us to hypothesize its use also for complex multi-material manufacts. Thus, chemical interactions between antifungal compounds and compositional materials could be avoided. This non-invasive treatment would be in line with the minimum intervention policies required for the restoration and mainainance of cultural heritage, although further experimentations are needed to assess its applicative aspects.
Availability of data and materials
Accession numbers of fungi sequences deposited on GenBank are reported in the text. The complete sequences are transcribed in the Additional file 1.
References
Branysova T, Demnerova K, Durovic M, Stiborova H. Microbial biodeterioration of cultural heritage and identification of the active agents over the last two decades. J Cult Herit. 2022;55:245–60. https://doi.org/10.1016/j.culher.2022.03.013.
Ranalli G, Zanardini E, Sorlini C. Biodeterioration–including cultural heritage, in encyclopedia of microbiology. Amsterdam: Elsevier; 2009. p. 191–205.
Zmeu CN, Bosch-Roig P. Risk analysis of biodeterioration in contemporary art collections: the poly-material challenge. J Cult Herit. 2022;58:33–48. https://doi.org/10.1016/j.culher.2022.09.014.
Mohanan N, Montazer Z, Sharma PK, Levin DB. Microbial and enzymatic degradation of synthetic plastics. Front Microbiol. 2020;11:580709. https://doi.org/10.3389/fmicb.2020.580709.
Cappitelli F, Villa F, Sanmartín P. Interactions of microorganisms and synthetic polymers in cultural heritage conservation. Int Biodeter Biodegr. 2021;163:105282. https://doi.org/10.1016/j.ibiod.2021.105282.
Kakakhel MA, Wu F, Gu J-D, Feng H, Shah K, Wang W. Controlling biodeterioration of cultural heritage objects with biocides: a review. Int Biodeter Biodegr. 2019;143:104721. https://doi.org/10.1016/j.ibiod.2019.10472.
Lukošiūtė S, Šernaitė L, Morkeliūnė A, Rasiukevičiūtė N, Valiuškaitė A. The effect of Lamiaceae plants essential oils on fungal plant pathogens in vitro. Agron Res. 2020;18:2761–9. https://doi.org/10.15159/ar.20.225.
Diánez F, Santos M, Parra C, Navarro M, Blanco R, Gea F. Screening of antifungal activity of 12 essential oils against eight pathogenic fungi of vegetables and mushroom. Lett Appl Microbiol. 2018;67:400–10. https://doi.org/10.1111/lam.13053.
Ghavam M, Bacchetta G, Castangia I, Manca ML. Evaluation of the composition and antimicrobial activities of essential oils from four species of Lamiaceae Martinov native to Iran. Sci Rep. 2022;12:17044. https://doi.org/10.1038/s41598-022-21509-5.
Karpiński TM. Essential oils of Lamiaceae family plants as antifungals. Biomolecules. 2020;10:103. https://doi.org/10.3390/biom10010103.
Dhifi W, Bellili S, Jazi S, Bahloul N, Mnif W. Essential oils’ chemical characterization and investigation of some biological activities: a critical review. Medicines. 2016;3:25. https://doi.org/10.3390/medicines3040025.
Wang S-Y, Chen P-F, Chang S-T. Antifungal activities of essential oils and their constituents from indigenous cinnamon (Cinnamomum osmophloeum) leaves against wood decay fungi. Bioresour Technol. 2005;96:813–8. https://doi.org/10.1016/j.biortech.2004.07.010.
Stupar M, Grbić ML, Džamić A, Unković N, Ristić M, Jelikić A, Vukojević J. Antifungal activity of selected essential oils and biocide benzalkonium chloride against the fungi isolated from cultural heritage objects. S Afr J Bot. 2014;93:118–24. https://doi.org/10.1016/j.sajb.2014.03.016.
Mehalaine S, Chenchouni H. Quantifying how climatic factors influence essential oil yield in wild-growing plants. Arab J Geosci. 2021;14:1257. https://doi.org/10.1007/s12517-021-07582-6.
Figueiredo AC, Barroso JG, Pedro LG, Scheffer JJ. Factors affecting secondary metabolite production in plants: volatile components and essential oils, Flavour. Fragr J. 2008;23:213–26. https://doi.org/10.1002/ffj.1875.
Soni U, Brar S, Gauttam VK. Effect of seasonal variation on secondary metabolites of medicinal plants. Int J Pharm Sci Res. 2015;6:3654–62. https://doi.org/10.13040/IJPSR.0975-8232.6(9).
Araus K, Uquiche E, del Valle JM. Matrix effects in supercritical CO2 extraction of essential oils from plant material. J Food Eng. 2009;92:438–47. https://doi.org/10.1016/j.jfoodeng.2008.12.016.
Walasek-Janusz M, Grzegorczyk A, Zalewski D, Malm A, Gajcy S, Gruszecki R. Variation in the antimicrobial activity of essential oils from cultivars of Lavandula angustifolia and L.× intermedia. Agronomy. 2022;12:2955. https://doi.org/10.3390/agronomy12122955.
Hassan B, Zouheir C, Redouane B, Mohammed C, Mustapha EM, Elbachir H. Antifungal activity of the essential oils of Rosmarinus officinalis, Salvia officinalis, Lavandula dentata and Cymbopogon citratus against the mycelial growth of Fusarium oxysporum f. sp. albedinis. Arab J Med Aromat Plants. 2022;8:108–33. https://doi.org/10.48347/IMIST.PRSM/ajmap-v8i1.30676.
Wińska K, Mączka W, Łyczko J, Grabarczyk M, Czubaszek A, Szumny A. Essential oils as antimicrobial agents—myth or real alternative? Molecules. 2019;24:2130. https://doi.org/10.3390/molecules24112130.
Caprari C, Fantasma F, Monaco P, Divino F, Iorizzi M, Ranalli G, Fasano F, Saviano G. Chemical Profiles, in vitro antioxidant and antifungal activity of four different Lavandula angustifolia L. EOs. Molecules. 2023;28:392. https://doi.org/10.3390/molecules28010392.
Danh LT, Han LN, Triet NDA, Zhao J, Mammucari R, Foster N. Comparison of chemical composition, antioxidant and antimicrobial activity of lavender (Lavandula angustifolia L.) essential oils extracted by supercritical CO2, hexane and hydrodistillation. Food Bioprocess Technol. 2013;6:3481–9. https://doi.org/10.1007/s11947-012-1026-z.
Bahmani M, Schmidt O. Plant essential oils for environment-friendly protection of wood objects against fungi. Maderas Cienc tecnol. 2018;20:325–32. https://doi.org/10.4067/S0718-221X2018005003301.
D’auria F, Tecca M, Strippoli V, Salvatore G, Battinelli L, Mazzanti G. Antifungal activity of Lavandula angustifolia essential oil against Candida albicans yeast and mycelial form. Med Mycol. 2005;43:391–436. https://doi.org/10.1080/13693780400004810.
Mandras N, Nostro A, Roana J, Scalas D, Banche G, Ghisetti V, Del Re S, Fucale G, Cuffini AM, Tullio V. Liquid and vapour-phase antifungal activities of essential oils against Candida albicans and non-albicans Candida. BMC Complement Altern Med. 2016;16:330. https://doi.org/10.1186/s12906-016-1316-5.
Sterflinger K, Pinzari F. The revenge of time: fungal deterioration of cultural heritage with particular reference to books, paper and parchment. Environ Microbiol. 2012;14:559–66. https://doi.org/10.1111/j.1462-2920.2011.02584.x.
Mijatovic S, Stankovic JA, Calovski IC, Dubljanin E, Pljevljakusic D, Bigovic D, Dzamic A. Antifungal activity of Lavandula angustifolia essential oil against Candida albicans: time-kill study on pediatric sputum isolates. Molecules. 2022;27:6300. https://doi.org/10.3390/molecules27196300.
Sumalan RM, Kuganov R, Obistioiu D, Popescu I, Radulov I, Alexa E, Negrea M, Salimzoda AF, Sumalan RL. CocanI Assessment of mint, basil, and lavender essential oil vapor-phase in antifungal protection and lemon fruit quality. Molecules. 2020;25:1831. https://doi.org/10.3390/molecules25081831.
Álvarez-García S, Moumni M, Romanazzi G. Antifungal activity of volatile organic compounds from essential oils against the postharvest pathogens Botrytis cinerea, Monilinia fructicola, Monilinia fructigena, and Monilinia laxa. Front Plant Sci. 2023;14:1274770. https://doi.org/10.3389/fpls.2023.1274770.
Rakotonirainy MS, Lavédrine B. Screening for antifungal activity of essential oils and related compounds to control the biocontamination in libraries and archives storage areas,". Int Biodet Biodeg. 2005;55:141–7. https://doi.org/10.1016/j.ibiod.2004.10.002.
Zhang Y, Wang Y, Zhao X, Liu L, Xing R, Song X, et al. Study on the anti-biofilm mechanism of 1, 8-cineole against Fusarium solani species complex. Front Pharmacol. 2022;13:1010593. https://doi.org/10.3389/fphar.2022.1010593.
Pop DM, Timar MC, Varodi AM, Beldean EC. An evaluation of clove (Eugenia caryophyllata) essential oil as a potential alternative antifungal wood protection system for cultural heritage conservation. Maderas Cienc tecnol. 2022;24:11. https://doi.org/10.4067/s0718-221x2022000100411.
Elsayed Y, Shabana Y. The Effect of some essential oils on Aspergillus niger and Alternaria alternata infestation in archaeological oil paintings. Mediterr Archaeol Archaeom. 2018;18:71–87. https://doi.org/10.5281/zenodo.1461616.
Gatti L, Troiano F, Vacchini V, Cappitelli F, Balloi A. An in vitro evaluation of the biocidal effect of oregano and cloves’ volatile compounds against microorganisms colonizing an oil painting—a pioneer study. Appl Sci. 2020;11:78. https://doi.org/10.3390/app11010078.
Sparacello S, Gallo G, Faddetta T, Megna B, Nicotra G, Bruno B, et al. Thymus vulgaris essential oil and hydro-alcoholic solutions to counteract wooden artwork microbial colonization. Appl Sci. 2021;11:8704. https://doi.org/10.3390/app11188704.
Palla F, Bruno M, Mercurio F, Tantillo A, Rotolo V. Essential oils as natural biocides in conservation of cultural heritage. Molecules. 2020;25:730. https://doi.org/10.3390/molecules25030730.
Palla F. Plant products as biocides for conservation of cultural asset sustainable for human and environmental health. J Basic Appl Sci. 2022;18:119–25. https://doi.org/10.29169/1927-5129.2022.18.12.
Palla F, Caruana E, Di Carlo E, Rotolo V. Plant essential oils in controlling fungal colonization on wooden substrate. Borziana. 2021;2:5–14. https://doi.org/10.7320/Borz.002.001.
Conlon BH, Schmidt S, Poulsen M, Shik JZ. Orthogonal protocols for DNA extraction from filamentous fungi. STAR protoc. 2022;3:101126. https://doi.org/10.1016/j.xpro.2022.101126.
Balouiri M, Sadiki M, Ibnsouda SK. Methods for in vitro evaluating antimicrobial activity: a review. J Pharm Anal. 2016;6:71–9. https://doi.org/10.1016/j.jpha.2015.11.005.
Raper KB, Fennell DI. The genus Aspergillus. Baltimore: Williams & Wilkins; 1965.
Rapper K, Thom C, Fennell D. A manual of the Penicillia. Baltimore: Willians & Wilkins; 1949.
Zare R, Gams W. The genera Lecanicillium and Simplicillium gen. nov. Nova Hedwigia. 2001;73:1–50.
Nouri MT, Lawrence DP, Holland LA, Doll DA, Kallsen CE, Culumber CM, et al. Identification and pathogenicity of fungal species associated with canker diseases of pistachio in California. Plant Dis. 2019;103:2397–411. https://doi.org/10.1094/PDIS-10-18-1717-RE.
Cáceres O, Kirschner R, Piepenbring M, Schöfer H, Gené J. Hormographiella verticillata and an Ozonium stage as anamorphs of Coprinellus domesticus. Antonie Van Leeuwenhoek. 2006;89:79–90. https://doi.org/10.1007/s10482-005-9011-4.
De Filpo G, Palermo AM, Tolmino R, Formoso P, Nicoletta FP. Gellan gum hybrid hydrogels for the cleaning of paper artworks contaminated with Aspergillus versicolor. Cellulose. 2016;23:3265–79. https://doi.org/10.1007/s10570-016-1021-z.
Tovar-Herrera OE, Martha-Paz AM, Pérez-LLano Y, Aranda E, Tacoronte-Morales JE, Pedroso-Cabrera MT, et al. Schizophyllum commune: an unexploited source for lignocellulose degrading enzymes. MicrobiologyOpen. 2018;7:e00637. https://doi.org/10.1002/mbo3.637.
Manici LM, De Meo I, Saccà LM, Ceotto E, Caputo F, Paletto A. The relationship between tree species and wood colonising fungi and fungal interactions influences wood degradation. Ecol Indic. 2023;151:110312. https://doi.org/10.1016/j.ecolind.2023.110312.
Gómez-Vidal S, Lopez-Llorca L, Jansson HB, Salinas J. Endophytic colonization of date palm (Phoenix dactylifera L.) leaves by entomopathogenic fungi. Micron. 2006;37:624–32. https://doi.org/10.1016/j.micron.2006.02.003.
Kiran Babu GD, Sharma A, Singh B. Volatile composition of Lavandula angustifolia produced by different extraction techniques. J Essent Oil Res. 2016;28:489–500. https://doi.org/10.1080/10412905.2016.1162210.
Tăbărașu AM, Anghelache DN, Găgeanu I, Biriș SȘ, Vlăduț NV. Considerations on the use of active compounds obtained from lavender. Sustainability. 2023;15:8879. https://doi.org/10.3390/su15118879.
Nađalin V, Lepojević Ž, Ristić M, Vladić J, Nikolovski B, Adamović D. Investigation of cultivated lavender (Lavandula officinalis L.) extraction and its extracts. Chem Ind Chem Eng Q. 2014;20:71–86. https://doi.org/10.2298/CICEQ120715103N.
Dębczak A, Tyśkiewicz K, Fekner Z, Kamiński P, Florkowski G, Konkol M, et al. Molecular distillation of lavender supercritical extracts: physicochemical and antimicrobial characterization of feedstocks and assessment of distillates enriched with oxygenated fragrance components. Molecules. 2022;27:1470. https://doi.org/10.3390/molecules27051470.
Alseekh S, Aharoni A, Brotman Y, Contrepois K, D’Auria J, Ewald J, et al. Mass spectrometry-based metabolomics: a guide for annotation, quantification and best reporting practices. Nat Methods. 2021;18:747–56. https://doi.org/10.1038/s41592-021-01197-1.
Jiang MH, Yang L, Zhu L, Piao JH, Jiang JG. Comparative GC/MS analysis of essential oils extracted by 3 methods from the bud of Citrus aurantium L. var. amara Engl. J Food Sci. 2011;76:C1219–25. https://doi.org/10.1111/j.1750-3841.2011.02421.x.
Brilhante RSN, Caetano EP, de Lima RAC, de Marques FJF, de Castelo-Branco DSCM, de Melo CVS, et al. Terpinen-4-ol, tyrosol, and β-lapachone as potential antifungals against dimorphic fungi. Braz J Microbiol. 2016;47:917–24. https://doi.org/10.1016/j.bjm.2016.07.015.
Finney D. Probit analysis. Cambridge: Cambridge University Press; 1971.
Caprari C, Fantasma F, Divino F, Bucci A, Iorizzi M, Naclerio G, et al. Chemical profile, in vitro biological activity and comparison of essential oils from fresh and dried flowers of Lavandula angustifolia L. Molecules. 2021;26:5317. https://doi.org/10.3390/molecules26175317.
Puškárová A, Bučková M, Kraková L, Pangallo D, Kozics K. The antibacterial and antifungal activity of six essential oils and their cyto/genotoxicity to human HEL 12469 cells. Sci Rep. 2017;7:8211. https://doi.org/10.1038/s41598-017-08673-9.
Acknowledgements
Not applicable.
Funding
This research did not receive any specific grant from funding agencies in the public, commercial, or not-for-profit sectors.
Author information
Authors and Affiliations
Contributions
BP was responsible for drafting the paper and carrying out the experimentation; MCS performed the identification of fungal species, contributed to microbiological assays, and revised the manuscript; MDC conducted the GC–MS analysis; JT supervised the GC–MS analysis; PK conducted the CO2 extraction and contributed to the relevant paragraph; EL supervised the microbiological assays and revised the manuscript; SP conducted the UHPLC-MS analysis, conceptualized the experimentation, supervised the work, and revised the manuscript.
Corresponding authors
Ethics declarations
Ethics approval and consent to participate
Not applicable.
Competing interests
The authors declare that they have no competing interests.
Additional information
Publisher's Note
Springer Nature remains neutral with regard to jurisdictional claims in published maps and institutional affiliations.
Supplementary Information
Additional file 1: Figure S1. (download DOCX )
Diagram of the pilot custom-built plant for supercritical extraction with carbon dioxide. Figure S2. Description line of genetic sequences.
Rights and permissions
Open Access This article is licensed under a Creative Commons Attribution 4.0 International License, which permits use, sharing, adaptation, distribution and reproduction in any medium or format, as long as you give appropriate credit to the original author(s) and the source, provide a link to the Creative Commons licence, and indicate if changes were made. The images or other third party material in this article are included in the article's Creative Commons licence, unless indicated otherwise in a credit line to the material. If material is not included in the article's Creative Commons licence and your intended use is not permitted by statutory regulation or exceeds the permitted use, you will need to obtain permission directly from the copyright holder. To view a copy of this licence, visit http://creativecommons.org/licenses/by/4.0/. The Creative Commons Public Domain Dedication waiver (http://creativecommons.org/publicdomain/zero/1.0/) applies to the data made available in this article, unless otherwise stated in a credit line to the data.
About this article
Cite this article
Paolino, B., Sorrentino, M.C., Troisi, J. et al. Lavandula angustifolia mill. for a suitable non-invasive treatment against fungal colonization on organic-media cultural heritage. Herit Sci 12, 53 (2024). https://doi.org/10.1186/s40494-024-01166-9
Received:
Accepted:
Published:
Version of record:
DOI: https://doi.org/10.1186/s40494-024-01166-9
Keywords
This article is cited by
-
Lavender essential oil for a contactless application for contemporary art conservation: a case study
npj Heritage Science (2025)
-
Greener solutions for biodeterioration of organic-media cultural heritage: where are we?
Heritage Science (2024)
-
Exploring airborne fungal contaminations and air quality pollution in nine ancient stone temples, Surin, Thailand
Environmental Science and Pollution Research (2024)